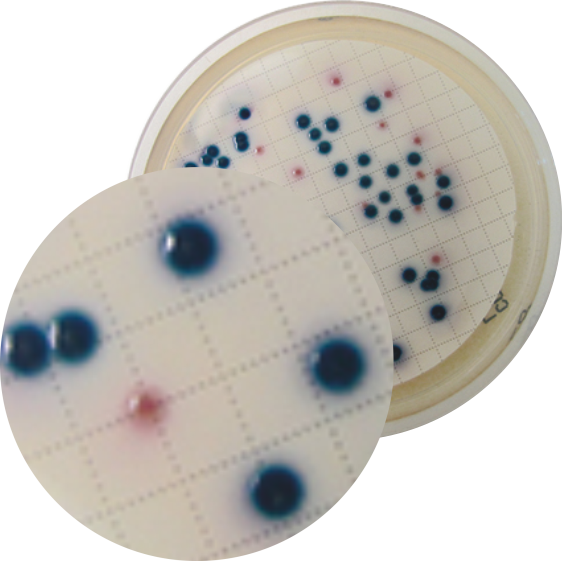

COMPASS® cc
COMPASS® CC Agar
İçme suyu örneklerinde E.coli / coliform sayımı için geliştirilmiştir.
Performans
- Oksidaz tespiti veya triptofanın indol üretimi gibi tipik doğrulama testlerine gerek yoktur.
- 24 saatte tespit sağlar.
Kolay
- Besiyerine kontrast oluşturacak şekilde E.coli mavi- viole renkte koloniler oluşturur.
- Koliformlar pembe renkte koloniler oluşturur.
Seçicilik
- Çok az sayıda bakteri içeren ya da yüksek oranda rekabetçi bakteri içeren, daha fazla kirlenmiş su kaynaklarından arıtılmış su ve diğer içilebilir su kaynaklarının su kontrolüne de uyarlanabilir.
Güvenilir
- ISO 9308-1 standardı referans alınarak ISO 16140 alternatif metot validasyon standardı kapsamında AFNOR tarafından BKR 23 / 08-06 / 12 referans numarası ile valide edilmiştir.